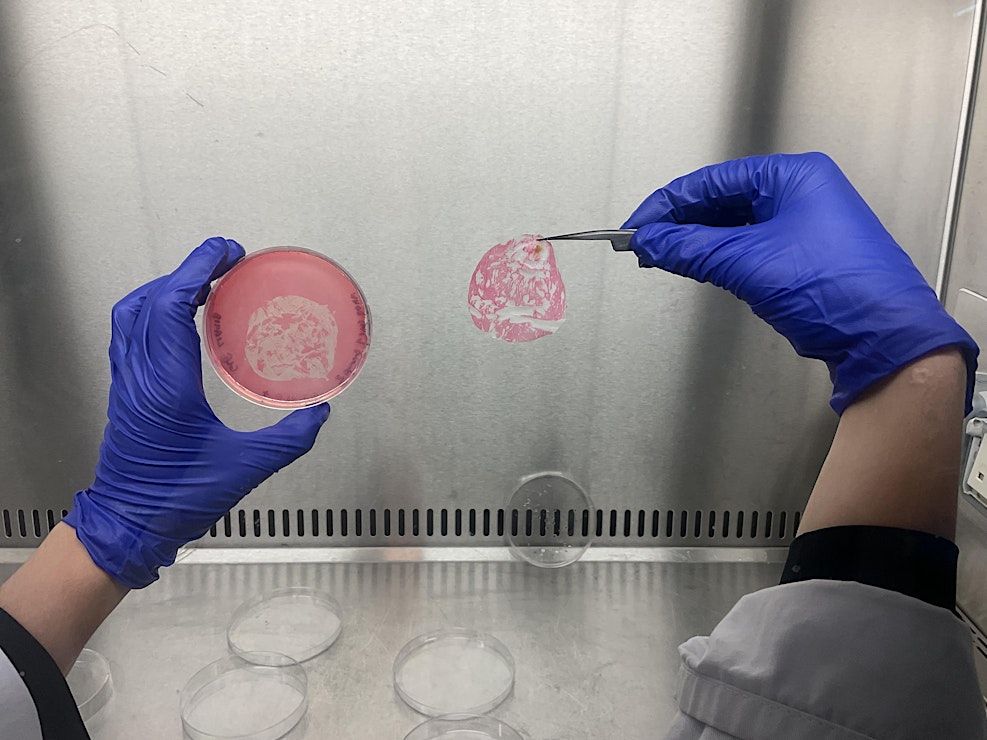
Event Photos

DIY Lab Techniques
Schedule
Sun Apr 19 2026 at 05:00 pm to 06:30 pm
UTC+01:00Location
Four Otter Craft Studio | London, EN

About this Event
Join this hands-on workshop introducing DIY lab practices – an accessible approach to working with biological techniques outside of traditional laboratory environments.
Focusing on sterile technique, contamination awareness, and low-cost setups, this session explores how fundamental lab methods can be adapted for home, studio, or community use. Participants will learn how simple tools and thoughtful processes can enable safe and effective experimentation, opening up possibilities for bio-based making, cultivation, and research beyond institutional labs.
DIY lab practices are rooted in both scientific tradition and grassroots innovation. By understanding sterilisation, contamination control, and how to replicate key lab conditions with minimal equipment, practitioners can work more confidently with living systems — whether growing cultures, experimenting with biomaterials, or exploring microbiology at a small scale.
No prior experience with biology or lab work is needed.
What to expect
During the workshop you will:
Learn the difference between sterilisation and contamination, and why it matters
Understand how to set up and work in a “lab outside a lab” environment
Get familiar with essential DIY lab equipment and low-cost alternatives
Explore what kinds of biological practices are possible outside traditional labs
Observe live demonstrations of working in a still air box, applying sterile techniques, and innoculating plates. Work in pairs to innoculate your own plates and practice sterile techniques you can apply in your own studio, practice, or DIY lab.
Who is this for?
This workshop is perfect for:
Artists and makers working with living systems
Designers interested in bio-based processes
Students and researchers exploring hands-on methods
Citizen scientists and DIY biology enthusiasts
Anyone curious about accessible lab practices
Accessibility / Requirements
No previous experience required
Suitable for beginners
Please wear comfortable clothes suitable for a hands-on session
Meet your instructors
Weronika Turowska is a biodesigner and material researcher interested in regenerative design principles, innovation, and environmental, cultural storytelling. At Blunik Studio, Weronika experiments with living and circular materials, often drawing from biological processes, craft traditions, and waste streams. Her work seeks to create objects and systems that not only reduce environmental impact but also spark new narratives about our relationship with matter, microbes, and making. She has led workshops exploring biodesign and sensory engagement with science, and her work has been exhibited internationally at the New European Bauhaus in Brussels, London Design Festival, Biofabricate, and Lethaby Gallery.
https://www.blunikstudio.com/portfolio-2 https://www.instagram.com/blunikstudio/
Kirsten Tingle is a biodesigner and artist specialising in mycelium fabrication and regenerative painting. She teaches mycelium workshops with Lifefabs in Camden, and frequently guest lectures on Biodesign practice across London. Her paintings have been exhibited in The Chan Gallery in LA; Pioneer Works, Vent, Chashama, and Phyliss Harriman Gallery in NYC; Biocalibrate Symposia, Broadworks, The Lethaby Gallery, and Safehouse in London; The Guidecca Satellite in Venice, Italy; The Edinburgh Fringe Festival in Scotland; and The Kyoto Arts Center in Japan.
https://www.instagram.com/kirstentingle

Where is it happening?
Four Otter Craft Studio, River Park Road, London, United KingdomEvent Location & Nearby Stays:
GBP 25.00 to GBP 30.00

![50 Years of Greg Wilson [Extended Day Set]](https://cdn-ip.allevents.in/s/rs:fill:500:250/g:sm/sh:100/aHR0cHM6Ly9jZG4tYXouYWxsZXZlbnRzLmluL2V2ZW50czEwL2Jhbm5lcnMvMjE4ODE5ZTVjODRhOTc4MDUwODc5MjA1NjQ3NjQwNzRkMGYwYmExNGVmNWIxZjIyMThhYzk4OGE2NzhlZDZlNS1yaW1nLXcxMDI0LWg1NzYtZGMxOTE5MTktZ21pci5qcGc_dj0xNzY5NjkwMzc2.avif)










